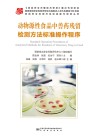
动物源性食品中兽药残留检测方法标准操作规程 封面

动物源性食品中兽药残留检测方法标准操作规程
丛书: 食品安全检测方法标准操作程序丛书
作者: 吴永宁
ISBN:978-7-5026-4873-2
关键词: 动物性食品-兽用药-残留量测定-标准-中国-技术操作规程
页数:426
出版社: 北京:中国标准出版社
出版日期:
发现《动物源性食品中兽药残留检测方法标准操作规程》在 2025-10-05 可全文阅读或下载。
图书简介
本书总结了动物源性食品中兽药残留检测方法的研制成果,并根据食品检验技术规范化要求,形成了对实际工作具有良好指导性的检验方法标准操作规程。本书首先从总体上论述了国内外兽药残留检测技术进展,并对动物性样品的采样和制备通用程序进行规范;其次从兽药的结构类型,本书分类别对其检测技术进行阐述,其中各类别检测技术既包括已经发布的兽药残留标准方法,也涵盖了近年来备受关注但尚无检测标准的兽药,如多粘菌素。此外,本书还以实例介绍了快速检测在动物性食品兽药残留检测中的应用以及兽药残留基体标准物质研制的典型案例。
用户须知
出版社通过教客网下载电子书并起诉站长多次,本站随时可能倒闭。
诉讼案号:(2022)川01民初4401,(2022)川01民初4403,(2022)川01民初4403,(2022)川0191民初19351号, (2022)川0191民初19594号,(2022)川0191民初20457号,(2022)川0191民初20459号, (2023)川知民终373号,(2023)川知民终374号,(2023)川知民终375号, (2024)川0191民初15977号,(2024)川0191民初15979号,(2024)川0191民初15980号, (2024)川0191民初15981号,(2024)川0191民初15982号
- 找《动物源性食品中兽药残留检测方法标准操作规程》,去就近图书馆。
- 本页面文字内容和图片来自 m.5read.com。
- 封皮图片引用地址:https://cover.duxiu.com/coverNew/CoverNew.dll?iid=726f686c6b6e68726f6a5fa7a898b09aad9eaba69aaba43636383836303139
